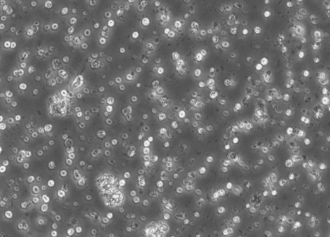

可选
请选择规格参数
产品简介
大鼠脾淋巴细胞完全培养基已包含大鼠脾淋巴细胞生长所需的各种成分,无需添加各种成分,可直接用于大鼠脾淋巴细胞的体外培养。
储存运输
冰袋冷藏运输,2℃-8℃,避光保存。
注意事项
1.收到培养基时,请及时检查外包装是否完好,是否损坏、漏液,如有请尽快联系。
2.本产品含有血清及生长因子,不易将其长时间放置于室温或较高的温度环境中。
3.本产品保质期三个月,请于保质期内使用。
4.请严格执行无菌操作,避免污染。

本产品仅供科研用途,不用于临床诊断!
江浙沪皖用户邮费为10元,其他地区用户邮费为20, 国际运费请咨询sales@xfnano.com。购买满 500.0 元免运费。如果库存显示为0, 请电话或邮件和销售确认,免费热线电话:400 025 3200邮件:sale@xfnano.com 感谢您的支持!